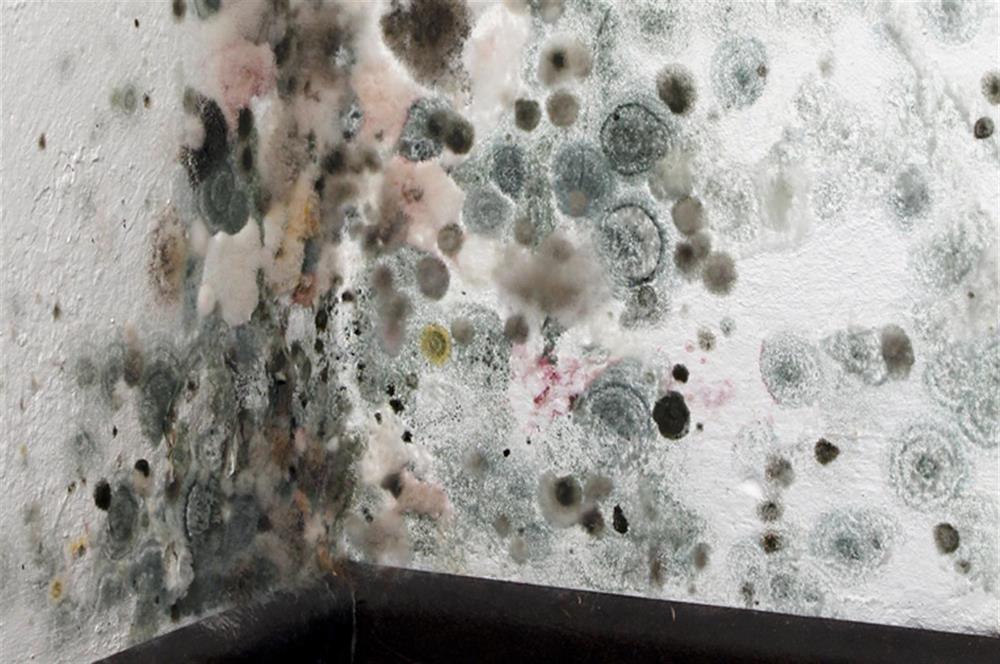

Nasty Mess To Clean Up? Steri-Fab It!
-
Neutralize bird droppings with Steri-Fab. Spray on bird & animal waste to neutralize harmful bacteria and parasites, making it safer for removal and proper disposal.
-
Use Steri-Fab as a surface bactericide, fungicide and deodorizer. Spray Steri-Fab on unhealthy gross filth to kill any bacteria and germs. When used as directed, Steri-Fab leaves the surface sanitized and deodorized.
-
Kills a wide spectrum of nasty insects. Steri-Fab is proven effective against roaches, mites, bedbugs, ants, silverfish, lice, louse eggs, fleas, ticks and other insects.
Steri-Fab Advantages;
-
Steri-fab can be applied to any inanimate (non-living) surface
-
Steri-fab is effective against most gram negative, gram positive and odor causing bacteria as well as insects, fungus, mold and mildew
-
Deodorizes and controls odor causing organisms on carpets
-
Provides for bacteriostatic, fungistatic and deodorization during restoration processes from smoke, water, and sewage backup damage
-
Sanitizes and deodorizes restrooms
-
One of the only non-residual products labeled for bed bugs on mattresses and upholstered furniture
-
One of the only products labeled for control of dust mites
-
One of the only products labeled for lice control on various surfaces
-
Dries in 15 to 20 minutes at room temperature
-
Is biodegradable, and leaves no residue or active ingredients
-
Steri-fab can be sprayed on everything except people, animals and cooking utensils.
-
Highly effective against bedbugs, fleas, ticks, and a host of other insects
* Sterifab may not be compatible with wax finishes.
Sterifab®: How to Get Rid of Bed Bugs - Fast!
Bed Bugs are parasitic insects that feed exclusively on blood. And while they can’t fly, they can nevertheless move quickly over floors, walls and ceilings. As a rule, they prefer warm places like houses, offices, hotel rooms, day care centers, hospitals, virtually anywhere humans dwell but they are especially drawn to beds, bedding and other sleep areas. Although they are usually active at night, bed bugs are not entirely nocturnal.
There's no easy bed bug treatment. Bed bugs are resilient insects and they can go several months without feeding. If you have the slightest suspicion that you have a bed bug infestation, don’t hesitate. If you want to know how to get rid of bed bugs, search no further. Track down the source immediately and use Sterifab before they become well-established and proliferate.
Here's how to get rid of bed bugs so they never return in 5 easy steps:
-
Remove any clutter, including stacks of paper or piles of laundry.
-
Treat all affected areas with Sterifab bed bug spray.
-
Clean all the affected rooms thoroughly.
-
Vacuum beds, carpets, chairs, drapes, blinds and more.
-
Wash all sheets and bedding in HOT water.
Contrary to popular belief, bed bugs can invade the cleanest of places and the victims often have no idea where they came from or how to get rid of them!
Bed Bugs: What to Look For
Bed bugs are small, oval and brownish in color and adult bed bugs have flat bodies about the size of an apple seed. After feeding, their bodies swell and turn a reddish color. They usually enter a home undetected, carried in with luggage, clothing, used beds and couches and other innocuous items.
Unfortunately, their flat bodies make it easy for them to fit into very small tiny spaces. Bed bugs can quickly and easily spread from bedrooms to other rooms or apartments, preferring to live in crevices or other protected locations.
Unlike ants or bees, bed bugs don’t make nests, but they do have a tendency to live in groups. Their primary hiding places are mattresses, box springs, bed frames and headboards, where they have easy access to their main source of blood, people. That's also why it's so hard to know what gets rid of bed bugs.
To Kill COVID-19
Despite global vaccination efforts, it looks like COVID is here to stay. At home, at work and in social interactions, protecting family, friends and others will continue to be on our minds.
It’s now EPA-official: Sterifab kills the virus on surfaces and offers one of the best ways to ensure your environment is COVID-free.
Does Sterifab Kill COVID - FAQ?
Yes. Sterifab is EPA registered and can kill 99.9% of SARS-CoV-2, the virus that causes COVID-19. Based on extensive laboratory testing reviewed and approved by the EPA, Sterifab was shown to kill SARS-CoV-2 upon application.
Odorless and non-residual, Sterifab is ideal for disinfecting areas that may have been exposed to the virus. It can be used on mattresses, counters, couches and more. Simply spray, wait 10-15 minutes and then return to normal use of the room.
Like many disinfectants, Sterifab is an antimicrobial agent that will kill many microorganisms on contact. Unlike antibiotics, which are designed to destroy microorganisms within the body, disinfectants like Sterifab work by destroying the microbes at the cellular level or hindering their basic metabolic functions. That’s why Sterifab is commonly used in hospitals, prisons, dental surgeries, kitchens, bathrooms, offices - anywhere that humans live or work.
Sterifab: The Anywhere, Anytime Disinfectant
One thing that sets Sterifab apart is its versatility - it really is all-purpose. Oftentimes people think that the best disinfectant to use depends on their particular situation. Some brands are designed to kill diverse sorts of microorganisms (these are referred to as being ‘wide spectrum’); others may be designed to eradicate a smaller assortment of microorganisms.
Sterifab Kills Viruses, Bed Bugs, Bacteria & More Uses
The nonresidual spray deodorizes as it disinfects and is the only EPA-registered virucide, disinfectant and insecticide in one product.
Steri-Fab® Multi-Purpose sanitizer, virucide, germicide, fungicide, mildewcide and disinfectant
Steri-Fab® Kills Bed Bugs, Fleas, Ticks, Mites, Mold and More.
Sterifab is EPA registered and will kill 99.9% of SARS-CoV-2, the virus that causes COVID-19
Steri-Fab Multi-Purpose sanitizer, virucide, germicide, fungicide, mildewcide, disinfectant, and Insecticide that kills bed bugs, lice, fleas, ticks and dust mites and other insects. No mixing, safe and easy to apply. (Not for use in foggers)
Steri-Fab is wide spectrum surface disinfectant and cleaner that can be sprayed on almost any surface without fear of staining or odors. It leaves no residue - once it dries (15 to 20 minutes at room temperature) it is no longer active and becomes completely inert.
Steri-Fab is the only product that is both a disinfectant and kills bedbugs. This is a ready-to-use (RTU) product, No Mixing Needed.
NOTE: NO AIR DELIVERY for Steri-Fab. Ground shipping only!
DO NOT CHOOSE AIR SHIPPING DURING CHECKOUT
NOTE: DO NOT USE STERI-FAB IN CONJUNCTION WITH MICROCIDE SQ. Use one product or the other - never both.
NOTE: DO NOT USE STERI-FAB IN FLAME OR SPARK PRODUCING EQUIPMENT.
(DO NOT use in ANY type of fogger)